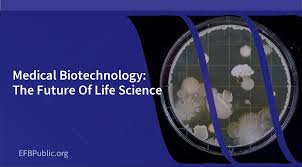

Doctor of Philosophy (Ph.D.) in Pathology is a rigorous 5-7 year research-focused doctoral program that prepares students for careers as leading experts in the study of disease. The curriculum covers advanced topics in anatomical, clinical, and molecular pathology, as well as research methods and biostatistics. Ph.D. candidates conduct original laboratory research and complete a doctoral dissertation that makes a significant contribution to the understanding of the causes, mechanisms, and diagnoses of human diseases. Graduates are equipped to work as pathologists, medical researchers, university professors, and consultants in hospitals, government agencies, and private biotechnology companies. The Ph.D. in Pathology provides students with the specialized expertise needed to advance the field of diagnostic medicine, develop new diagnostic tools and treatments, and improve patient outcomes.
Ph.D. in Pharmaceutics
Doctor of Philosophy (Ph.D.) in Pharmaceutics is a rigorous 5-7 year research-focused doctoral program that provides students to serve as leading specialists in the development and improvement of d...
Ph.D. in Pharmaceutics
×Doctor of Philosophy (Ph.D.) in Pharmaceutics is a rigorous 5-7 year research-focused doctoral program that provides students to serve as leading specialists in the development and improvement of drug delivery systems. The program includes advanced topics in pharmaceutical sciences such as pharmacokinetics, medication development, manufacturing methods, and regulatory issues. Ph.D. candidates perform original laboratory and clinical research, culminating in the submission of a doctoral dissertation which contributes significantly to the field of pharmaceutics. Graduates have been trained for positions as pharmaceutical scientists, university instructors, regulatory advisors, and R&D professionals in the pharmaceutical business. The Ph.D. in Pharmaceutics program equips students with the specific knowledge required to revolutionize drug delivery methods, improve patient outcomes, and impact the future of pharmaceutical product development.
Ph.D. in Oral Pathology And Microbiology
Ph.D. in Oral Pathology and Microbiology normally takes 3-5 years to complete, depending on the institution and research objectives. This postgraduate degree program focuses on disorders of the ora...
Ph.D. in Oral Pathology And Microbiology
×Ph.D. in Oral Pathology and Microbiology normally takes 3-5 years to complete, depending on the institution and research objectives. This postgraduate degree program focuses on disorders of the oral cavity, jaw, and adjacent structures, as well as the bacteria that cause these conditions. Students conduct substantial research, lab work, and clinical observations. The program includes topics such as oral histology, immunology, molecular biology, and sophisticated diagnostic procedures. Candidates are expected to do original research, publish in peer-reviewed publications, and defend their dissertations. This degree equips graduates to work in academia, research institutes, or specialized clinical practice, helping to enhance oral health diagnostics and treatments.
Ph.D. in Periodontology
Ph.D. in Periodontology is an advanced doctoral program typically lasting 3-5 years, focusing on the study and treatment of periodontal diseases and oral health. This research-intensive degree comb...
Ph.D. in Periodontology
×Ph.D. in Periodontology is an advanced doctoral program typically lasting 3-5 years, focusing on the study and treatment of periodontal diseases and oral health. This research-intensive degree combines clinical training with in-depth scientific investigation, preparing graduates for academic, research, or specialized clinical roles. Students engage in advanced coursework, conduct original research, and often participate in teaching. The curriculum covers topics such as periodontal pathology, regenerative techniques, implantology, and evidence-based dentistry. Candidates usually need a dental degree and may require specialty training in periodontology. Upon completion, graduates are equipped to contribute to the field through research, education, and advanced clinical practice.
Ph.D. in Medical Biochemistry
A Ph.D. in Medical Biochemistry explores the chemical processes that take place in the human body and is an advanced research degree that lasts 4-5 years. In-depth courses in physiology, molec...
Ph.D. in Medical Biochemistry
×A Ph.D. in Medical Biochemistry explores the chemical processes that take place in the human body and is an advanced research degree that lasts 4-5 years. In-depth courses in physiology, molecular biology, and biochemistry are combined with a rigorous research project in this program. Students become proficient in methods such as chromatography, bioinformatics, and spectroscopy to explore the biochemical processes that underlie both health and illness. Graduates are equipped for jobs in government organizations, biotechnology, pharmaceutical research, or academia where they can help create novel medical treatments, diagnostics, and therapies. Students gain critical thinking, problem-solving, and communication abilities that are highly regarded in the medical sciences thanks to the demanding curriculum and individual research project.
Ph.D. in Medical Microbiology
A doctorate degree in medical microbiology, which focuses on research, normally takes approximately 4-6 years to finish. Advanced training in the study of microbes, their interactions with hos...
Ph.D. in Medical Microbiology
×A doctorate degree in medical microbiology, which focuses on research, normally takes approximately 4-6 years to finish. Advanced training in the study of microbes, their interactions with hosts, and their role in illness is offered by the program. Microbial pathogenesis, immunology, epidemiology, and laboratory procedures are among the subjects covered in the coursework. Students show their proficiency in a particular field of medical microbiology by conducting original research, publishing findings, and defending a dissertation. Graduates are equipped for jobs in public health, academia, pharmaceutical and biotech research, and other domains that need proficiency in the identification, management, and prevention of infectious illnesses.
Ph.D. in Medical Physiology
A Ph.D. program in medical physiology, which lasts from 4-6 years, offers advanced instruction in the study of the human body's typical processes and activities. Topics including organ sys...
Ph.D. in Medical Physiology
×A Ph.D. program in medical physiology, which lasts from 4-6 years, offers advanced instruction in the study of the human body's typical processes and activities. Topics including organ system function, cellular and molecular physiology, and the integration of physiological processes are all covered in the curriculum. Graduates can go on to work in academia, research, or the pharmaceutical sector, advancing medical knowledge and creating novel cures and treatments.
Ph.D. in Medical Genetics
A doctorate in medical genetics normally takes 4-6 years to finish. Advanced research and study on the genetic foundations of human health and illness are the program's main areas of conce...
Ph.D. in Medical Genetics
×A doctorate in medical genetics normally takes 4-6 years to finish. Advanced research and study on the genetic foundations of human health and illness are the program's main areas of concentration. Clinical genetics, genomics, bioinformatics, and molecular genetics are among the subjects covered in the program. Students finish a unique research dissertation that advances the field's understanding. Graduates are equipped for professions in genetic counseling, biotechnology, medical research, and academia. The Ph.D. offers extensive proficiency in the use of genomic and genetic methods to comprehend, identify, and treat complicated diseases and inherited disorders.
Ph.D. in Medical Anatomy
The average time to earn a Ph.D. i.e., doctoral degree,in medical anatomy is 4-6 years. With a focus on medical applications, the curriculum emphasizes the advanced study of the human bo...
Ph.D. in Medical Anatomy
×The average time to earn a Ph.D. i.e., doctoral degree,in medical anatomy is 4-6 years. With a focus on medical applications, the curriculum emphasizes the advanced study of the human body's structure and function. Gross anatomy, histology, embryology, and neuroanatomy are among the subjects covered in the coursework. In order to contribute something new to the area, students also carry out original research and finish a dissertation. Alumni of this degree frequently go on to work in specialized healthcare positions requiring in-depth anatomical knowledge, academia, or medical research.
Ph.D. in Hospital Administration
Advanced training in healthcare management, policy, and administration is offered via a 4-5 year Ph.D. degree in Hospital Administration. Organizational behavior, quality improvement, strategi...
Ph.D. in Hospital Administration
×Advanced training in healthcare management, policy, and administration is offered via a 4-5 year Ph.D. degree in Hospital Administration. Organizational behavior, quality improvement, strategic planning, and healthcare economics are among the subjects covered in the curriculum. In addition, learners finish a dissertation and carry out unique research. Graduates frequently go on to hold executive positions in government organizations, healthcare systems, hospitals, or consulting firms, where they use their knowledge to enhance patient outcomes and streamline healthcare operations.
Ph.D. in. Anaesthesiology
Gaining proficiency in anesthesia, pain management, and critical care is the goal of an advanced research-focused Ph.D. program in anesthesiology. The course, which usually lasts 3-5 years, in...
Ph.D. in. Anaesthesiology
×Gaining proficiency in anesthesia, pain management, and critical care is the goal of an advanced research-focused Ph.D. program in anesthesiology. The course, which usually lasts 3-5 years, includes in-depth study of physiology, pharmacology, anesthesia methods, and patient safety. Anaesthetic medications, sophisticated monitoring systems, and control of perioperative hazards are just a few of topics that students investigate in their unique research. Graduates of program are prepared for positions in clinical practice, academic research, or leadership in healthcare organizations. A medical degree (MBBS or equivalent) and anesthesiology experience are typically requirements for applicants. Goal is to advance the field's theoretical understanding as well as its practical applications.
Ph.D. in Obstetrics & Gynaecology
Ph.D. in Obstetrics & Gynaecology is a research-based program that aims to further knowledge of women's health, including pregnancy, delivery, and reproductive system problems. The program...
Ph.D. in Obstetrics & Gynaecology
×Ph.D. in Obstetrics & Gynaecology is a research-based program that aims to further knowledge of women's health, including pregnancy, delivery, and reproductive system problems. The program typically lasts 3 to 5 years and covers topics such as maternal-fetal medicine, reproductive endocrinology, gynecological oncology, fertility treatments, and obstetric problems. Students conduct clinical and laboratory-based research to improve healthcare practices, create new medicines, and address issues in women's health. The program includes medical science courses, research methodology, and a dissertation based on unique research. Graduates frequently pursue professions in academic research, healthcare facilities, and medical practice.
Ph.D. in Pediatrics
Ph.D. in Pediatrics is a research-oriented degree that investigates children's health, growth, development, and diseases. The program typically lasts 3-5 years and covers areas such as ped...
Ph.D. in Pediatrics
×Ph.D. in Pediatrics is a research-oriented degree that investigates children's health, growth, development, and diseases. The program typically lasts 3-5 years and covers areas such as pediatric endocrinology, pediatric infectious illnesses, child development, pediatric nutrition, and child psychology. Students do clinical and laboratory research aimed at enhancing pediatric care, creating new treatments for childhood disorders, and understanding children's particular health requirements. The program requires coursework, research methods, and a dissertation. Graduates frequently pursue positions in academic research, pediatric medicine, healthcare institutions, and public health groups.
Ph.D. in Psychiatry
Ph.D. in Psychiatry is a research-intensive program that focuses on the scientific study of mental health disorders, their causes, and treatments. Typically lasting 3 to 5 years, the program covers...
Ph.D. in Psychiatry
×Ph.D. in Psychiatry is a research-intensive program that focuses on the scientific study of mental health disorders, their causes, and treatments. Typically lasting 3 to 5 years, the program covers topics such as neurobiology, psychopharmacology, clinical psychology, mental health assessment, and therapeutic interventions. Students engage in research to explore the biological, psychological, and social factors influencing mental illness, as well as the development of innovative treatments. The program includes coursework, research methodology, clinical training, and culminates in a dissertation. Graduates often pursue careers in academic research, clinical practice, or psychiatric healthcare institutions, contributing to the advancement of mental health care.
Ph.D. in Radio Diagnosis
Ph.D. in Radiodiagnosis is a research-oriented degree that enhances understanding of medical imaging techniques and their applications in identifying a variety of diseases and ailments. The curricu...
Ph.D. in Radio Diagnosis
×Ph.D. in Radiodiagnosis is a research-oriented degree that enhances understanding of medical imaging techniques and their applications in identifying a variety of diseases and ailments. The curriculum typically lasts 3 to 5 years and covers topics such as radiology, medical imaging technologies (CT, MRI, ultrasound, and X-rays), image processing, and diagnostic procedures. Students perform research to improve imaging procedures, increase diagnostic accuracy, and investigate new medical technology for better patient care. The program consists of coursework, research methods, and the production of a dissertation. Graduates of this degree frequently seek positions in academia, research, or advanced clinical responsibilities in medical institutions.
Ph.D. in Surgery
Ph.D. in Surgery is a research-intensive program that seeks to advance knowledge of surgical procedures, techniques, and innovations. Typically lasting 3 to 5 years, the curriculum entails extensiv...
Ph.D. in Surgery
×Ph.D. in Surgery is a research-intensive program that seeks to advance knowledge of surgical procedures, techniques, and innovations. Typically lasting 3 to 5 years, the curriculum entails extensive research in fields like as surgical anatomy, surgical pathology, minimally invasive surgery, transplant surgery, and the creation of novel medical technology. Students do both laboratory and clinical research to investigate surgery results, novel treatment options, and healthcare systems. The program culminates with a dissertation that advances surgical knowledge. Graduates frequently seek professions in academic research, teaching, surgical practice, and healthcare innovation.
Ph.D. in Community Medicine
Ph.D. in Community Medicine is a research-based program that provides students with advanced knowledge of public health, epidemiology, and social medicine. The program, which usually lasts 3 to 5 y...
Ph.D. in Community Medicine
×Ph.D. in Community Medicine is a research-based program that provides students with advanced knowledge of public health, epidemiology, and social medicine. The program, which usually lasts 3 to 5 years, covers topics like health policy, preventive medicine, global health, healthcare management, and environmental health. Students do both academic coursework and practical research, with the goal of improving community health outcomes. The dissertation is an important component of the program, as it addresses real-world public health challenges. Graduates frequently pursue positions in academia, healthcare leadership, government or non-government organizations, and public health research.
Ph.D. in Physiology
Ph.D. in Physiology is an advanced research-focused degree that normally lasts 3-5 years. It entails a thorough examination of biological systems, with emphasis on functions such as cellular p...
Ph.D. in Physiology
×Ph.D. in Physiology is an advanced research-focused degree that normally lasts 3-5 years. It entails a thorough examination of biological systems, with emphasis on functions such as cellular processes, organ systems, and homeostasis. Students study neurophysiology, cardiovascular physiology, endocrinology, and exercise physiology. The program consists of demanding coursework, thorough tests, and original research, culminating in a dissertation. This degree prepares students for positions in academia, healthcare, pharmaceuticals, and research institutions. A Ph.D. in Physiology focuses on developing critical thinking, experimental abilities, and a thorough grasp of the systems that control bodily functioning.
Ph.D. in Public Health
Ph.D. in Public Health is an advanced research degree focused on developing expertise in public health practices, epidemiology, and health policy. Typically completed in 3 - 5 years, the program co...
Ph.D. in Public Health
×Ph.D. in Public Health is an advanced research degree focused on developing expertise in public health practices, epidemiology, and health policy. Typically completed in 3 - 5 years, the program combines rigorous coursework with original research, allowing candidates to specialize in areas like epidemiology, health systems, global health, or biostatistics. Students are trained in advanced methodologies for assessing health outcomes, managing public health initiatives, and addressing health disparities. Graduates are prepared for careers in academia, research institutions, government health agencies, or NGOs, where they can influence health policy, lead public health programs, and conduct impactful research.
Ph.D. in Medical Physics
Ph.D. in Medical Physics typically takes 4-6 years to complete, building upon a strong foundation in physics, mathematics, and biology. This interdisciplinary program combines principles of physics...
Ph.D. in Medical Physics
×Ph.D. in Medical Physics typically takes 4-6 years to complete, building upon a strong foundation in physics, mathematics, and biology. This interdisciplinary program combines principles of physics with medical applications, preparing students for careers in healthcare, research, and academia. Coursework covers topics such as radiation therapy, diagnostic imaging, nuclear medicine, and health physics. Students engage in advanced research, often collaborating with hospitals and medical centers to develop innovative medical technologies. The curriculum includes hands-on clinical experience, laboratory work, and a doctoral dissertation. Graduates are equipped to contribute to cutting-edge medical treatments, improve diagnostic techniques, and enhance patient care through the application of physics in medicine.
Ph.D. in Medical and Health Science
Ph.D. in Medical and Health Science is a research-intensive program that typically spans 3-5 years, focusing on advancing knowledge in medical sciences, healthcare delivery, and public health. This...
Ph.D. in Medical and Health Science
×Ph.D. in Medical and Health Science is a research-intensive program that typically spans 3-5 years, focusing on advancing knowledge in medical sciences, healthcare delivery, and public health. This program emphasizes original research, often involving clinical or biomedical studies, public health analysis, or healthcare policy development. Students work under faculty mentorship, gaining expertise in research methodologies, critical analysis, and scientific writing. Ph.D. candidates often specialize in areas such as epidemiology, molecular medicine, or health systems management. Graduates contribute to academia, healthcare research institutions, or governmental health agencies, helping to improve health outcomes through innovative solutions and evidence-based practices.
Ph.D. in General Medicine
Ph.D. in General Medicine is an advanced research degree that focuses on discovering and expanding knowledge in internal medicine, diagnostics, and patient care for a variety of medical disorders....
Ph.D. in General Medicine
×Ph.D. in General Medicine is an advanced research degree that focuses on discovering and expanding knowledge in internal medicine, diagnostics, and patient care for a variety of medical disorders. The curriculum typically lasts 3-5 years and includes extensive training in research methodology, clinical trials, and in-depth study of fields such as cardiology, endocrinology, infectious diseases, and others. Students perform original research, which frequently seeks to improve diagnostic tools, treatment regimens, and healthcare outcomes. Graduates are well-prepared to work in academic research, clinical practice development, and healthcare leadership, helping to promote medical knowledge and patient-centered treatment.
Ph.D. in Ear, Nose And Throat
Ph.D. in Ear, Nose, and Throat (ENT) studies advanced medical and surgical treatments for problems affecting the ear, nose, and throat, such as hearing, balance, respiratory system, and relat...
Ph.D. in Ear, Nose And Throat
× Ph.D. in Ear, Nose, and Throat (ENT) studies advanced medical and surgical treatments for problems affecting the ear, nose, and throat, such as hearing, balance, respiratory system, and related structures. The program, which lasts 3 to 5 years, integrates education in anatomy, physiology, otolaryngology, audiology, and surgical methods with original clinical or lab research. Students investigate hearing loss, sinus diseases, voice disorders, and the influence of environmental variables on ENT health. Graduates are prepared to work in academia, medical research, or healthcare, helping to enhance ENT therapies, diagnostics, and surgical procedures.
Ph.D. in Prosthodontics and Crown and Bridge
PhD in Prosthodontics and Crown and Bridge focuses on the restoration and replacement of teeth using modern dental prosthetics such as crowns, bridges, dentures, and implants. The program, wh...
Ph.D. in Prosthodontics and Crown and Bridge
×PhD in Prosthodontics and Crown and Bridge focuses on the restoration and replacement of teeth using modern dental prosthetics such as crowns, bridges, dentures, and implants. The program, which typically lasts 3 to 5 years, includes instruction in dental materials, occlusion, biomaterials, and clinical procedures as well as intensive restorative dentistry research. Students learn about the design and production of fixed and detachable prostheses, implantology, and advances in prosthetic technology. Graduates are prepared to work in academia, clinical practice, and research, helping to promote prosthodontic practices, improve patient outcomes, and create new materials and technology for dental restoration.
Ph.D. in Public Health Dentistry
Ph.D. in Public Health Dentistry focuses on improving oral health at the community and population levels by combining dental care with public health methods. The curriculum typically lasts 3 to 5 y...
Ph.D. in Public Health Dentistry
×Ph.D. in Public Health Dentistry focuses on improving oral health at the community and population levels by combining dental care with public health methods. The curriculum typically lasts 3 to 5 years and includes courses in epidemiology, health policy, oral preventive, and community-based research, as well as significant fieldwork. Students investigate oral health inequities, dental disease prevention, health promotion, and the role of dentistry in public health systems. Graduates are equipped for careers in academia, research institutes, public health organizations, and government agencies, where they can help establish policies, programs, and strategies to enhance oral health at the population level.
Ph.D. in Oral Medicine and Radiology
Ph.D. in Oral Medicine and Radiology focuses on the diagnosis and treatment of oral disorders, with a particular emphasis on the use of radiographic techniques for diagnosis and planning. The...
Ph.D. in Oral Medicine and Radiology
× Ph.D. in Oral Medicine and Radiology focuses on the diagnosis and treatment of oral disorders, with a particular emphasis on the use of radiographic techniques for diagnosis and planning. The program typically lasts 3 to 5 years and includes courses in oral pathology, radiographic imaging, clinical medicine, and diagnostic procedures, as well as original research. Students learn about medical picture interpretation, modern diagnostic tools, and how to address problems such as oral cancer, TMJ disorders, and systemic diseases with oral symptoms. Graduates are well-prepared for positions in academia, clinical practice, and research, where they can help enhance diagnostic imaging and oral healthcare.
Ph.D. in Dentofacial Orthopaedics
Ph.D. in Dentofacial Orthopaedics focuses on the diagnosis and treatment of malocclusions and skeletal abnormalities of the face and jaw. The program, which typically lasts 3-5 years, in...
Ph.D. in Dentofacial Orthopaedics
×Ph.D. in Dentofacial Orthopaedics focuses on the diagnosis and treatment of malocclusions and skeletal abnormalities of the face and jaw. The program, which typically lasts 3-5 years, integrates instruction in orthodontics, craniofacial growth, biomechanics, and surgical intervention with significant research. Students study jaw development, face growth patterns, skeletal abnormalities, and the combination of orthodontics and orthopaedic therapy. Graduates of the program are prepared for jobs in academia, research, or specialized clinical practice, where they will advance knowledge of facial anatomy, improve treatment approaches, and contribute to breakthroughs in the diagnosis and management of complicated dentofacial disorders.
Ph.D. in Orthodontics
Ph.D. in Orthodontics is a research-intensive program that investigates the diagnosis, prevention, and treatment of dental and facial abnormalities. The program typically lasts 3 to 5 years a...
Ph.D. in Orthodontics
× Ph.D. in Orthodontics is a research-intensive program that investigates the diagnosis, prevention, and treatment of dental and facial abnormalities. The program typically lasts 3 to 5 years and includes courses in orthodontic theory, craniofacial development, biomechanics, and dental materials, as well as unique clinical and laboratory research. Students study growth trends, orthodontic appliances, craniofacial anomalies, and advances in digital orthodontics. Graduates are prepared for jobs in academia, research, or specialized orthodontic practice, where they can help to innovate treatment procedures, improve patient outcomes, and advance knowledge in orthodontics and dental care.
Ph.D. in Conservative Dentistry and Endodontics
Ph.D. in Conservative Dentistry and Endodontics is a highly specialized research degree that focuses on tooth preservation and restoration, as well as the diagnosis and treatment of dental pu...
Ph.D. in Conservative Dentistry and Endodontics
× Ph.D. in Conservative Dentistry and Endodontics is a highly specialized research degree that focuses on tooth preservation and restoration, as well as the diagnosis and treatment of dental pulp and root canal illnesses. The program typically lasts 3 to 5 years and includes instruction in dental materials, oral pathology, advanced endodontic procedures, and restorative dentistry, as well as original research. Students learn about tooth preservation techniques, root canal therapy advances, and the creation of novel materials and technologies in endodontics. Graduates are prepared to work in academia, clinical research, or specialty dentistry practice, helping to develop patient care and dental technologies.
Ph.D. in Oral and Maxillofacial Surgery
Ph.D. in Oral and Maxillofacial Surgery focuses on sophisticated research and clinical skills in surgical procedures for the mouth, jaws, face, and neck. The program normally lasts 3-5 y...
Ph.D. in Oral and Maxillofacial Surgery
× Ph.D. in Oral and Maxillofacial Surgery focuses on sophisticated research and clinical skills in surgical procedures for the mouth, jaws, face, and neck. The program normally lasts 3-5 years and includes education in surgical methods, anatomy, pathology, and patient care, as well as hands-on clinical training. Students learn about complex topics such as craniofacial reconstruction, trauma management, dental implants, and oral cancer treatments. Innovative surgical approaches, pain treatment, and healing strategies may all be part of the research. Graduates have the opportunity to work in academic research, advanced clinical practice, or specialized surgical roles in hospitals and dental facilities.
Ph.D. in Medical Pharmacology
The study of medications and how they affect biological systems is the main focus of Ph.D. in medical pharmacology, which normally takes 3-5 years to finish. Advanced courses on pharmaco...
Ph.D. in Medical Pharmacology
×The study of medications and how they affect biological systems is the main focus of Ph.D. in medical pharmacology, which normally takes 3-5 years to finish. Advanced courses on pharmacodynamics, pharmacokinetics, drug design, molecular pharmacology, and toxicology are also part of the program. Through laboratory research, students study medication processes, clinical uses, and disease treatment approaches. The curriculum is made to give students the tools they need to work in clinical, academic, or industrial research settings. Graduates frequently work at research institutes, pharmaceutical businesses, or healthcare settings, contributing to drug discovery, personalized medicine, and pharmacological breakthroughs.
Ph.D. in Ophthalmology
Ph.D. in Ophthalmology is a specialized research-based program that focuses on the study of eye diseases, disorders, and treatments. The course typically spans &nbs...
Ph.D. in Ophthalmology
×Ph.D. in Ophthalmology is a specialized research-based program that focuses on the study of eye diseases, disorders, and treatments. The course typically spans 3 -5 years and involves in-depth research, clinical training, and academic coursework. Students engage in advanced studies in areas such as ocular surgery, vision science, retinal diseases, corneal disorders, and neuro-ophthalmology. The program prepares candidates for careers in academic research, clinical practice, and medical innovation. Applicants must hold a medical degree (MBBS or equivalent), and the program often culminates in a doctoral thesis based on original research in the field of ophthalmology.
Ph.D. in Dermatology
Ph.D. in Dermatology is an advanced research-focused program designed to deepen knowledge in the study of skin diseases, disorders, and treatments. The course typically spans 3-5 years, depending o...
Ph.D. in Dermatology
×Ph.D. in Dermatology is an advanced research-focused program designed to deepen knowledge in the study of skin diseases, disorders, and treatments. The course typically spans 3-5 years, depending on the institution and research progress. Students are trained in molecular dermatology, immunodermatology, dermatopathology, and clinical dermatology, with a strong emphasis on conducting original research. Candidates must complete coursework, comprehensive exams, and a dissertation based on their research findings. The program prepares graduates for careers in academia, clinical practice, and dermatological research, equipping them with skills to contribute to advancements in skin care and treatment innovations.
Ph.D. in Emergency Medicine
Ph.D. in Emergency Medicine is a research-based doctoral program designed for professionals seeking advanced knowledge in emergency care, trauma management, and disaster response. The course typica...
Ph.D. in Emergency Medicine
×Ph.D. in Emergency Medicine is a research-based doctoral program designed for professionals seeking advanced knowledge in emergency care, trauma management, and disaster response. The course typically spans 3 - 5 years, depending on the institution and research progress. It focuses on medical research, clinical practice, policy development, and innovations in emergency care systems. Students explore topics like pre-hospital care, emergency medical technologies, critical care, and health systems management. The program combines academic coursework with hands-on clinical experience, preparing graduates for leadership roles in emergency departments, academia, or public health policy. A Ph.D. in Emergency Medicine offers opportunities to shape the future of urgent and critical care.
Ph.D. in Respiratory Medicine
Ph.D. in Respiratory Medicine is a specialized research-oriented program that focuses on advanced studies in pulmonary diseases, their diagnosis, treatment, and prevention. The course duration typi...
Ph.D. in Respiratory Medicine
×Ph.D. in Respiratory Medicine is a specialized research-oriented program that focuses on advanced studies in pulmonary diseases, their diagnosis, treatment, and prevention. The course duration typically ranges from 3 -5 years, depending on the institution and research progress. It encompasses in-depth research into respiratory physiology, pathology, clinical interventions, and the development of novel therapies. Students are expected to conduct original research, contribute to medical knowledge, and advance treatment options for diseases like asthma, COPD, tuberculosis, and lung cancer. Graduates of this program often pursue careers in academia, clinical research, or specialized respiratory medicine practice.
Ph.D. in Medical Surgical Nursing
Usually taking 4 - 6 years to finish, a Ph.D. in Medical Surgical Nursing is a terminal degree. Comprehensive instruction in medical-surgical nursing theory, research techniques, and clinical...
Ph.D. in Medical Surgical Nursing
×Usually taking 4 - 6 years to finish, a Ph.D. in Medical Surgical Nursing is a terminal degree. Comprehensive instruction in medical-surgical nursing theory, research techniques, and clinical practice is offered by the curriculum. Pathophysiology, pharmacology, evidence-based practice, and nursing leadership are among the subjects addressed in the coursework. In order to add fresh knowledge to the field, students finish a dissertation requiring distinctive research. Graduates are equipped to work in hospitals, universities, and other healthcare settings as advanced clinical practitioners, researchers, administrators, and nurse educators.
Ph.D. in Mental Health Nursing
The average time to finish a Ph.D. in Mental Health Nursing is 4 - 6 years. Advanced training in nursing theory, research techniques, and clinical practice with a particular focus on mental he...
Ph.D. in Mental Health Nursing
×The average time to finish a Ph.D. in Mental Health Nursing is 4 - 6 years. Advanced training in nursing theory, research techniques, and clinical practice with a particular focus on mental health and psychiatric care is offered by the program. Psychopharmacology, evidence-based therapies, and assessment of programs are among the subjects covered in the coursework. Students finish a dissertation that advances the field's original research. Graduates are equipped to work in mental health settings as advanced clinical practitioners, educators, administrators, and nurse scientists. The degree gives nurses the skills necessary for improving patient outcomes, shape policy, and increase the body of knowledge in mental healthcare throughout the nursing profession.
Ph.D. in Child Health Nursing
With an emphasis on cutting-edge research in pediatric healthcare, a Ph.D. in Child Health Nursing normally takes 3 - 5 years to finish. Coursework, independent study,...
Ph.D. in Child Health Nursing
×
With an emphasis on cutting-edge research in pediatric healthcare, a Ph.D. in Child Health Nursing normally takes 3 - 5 years to finish. Coursework, independent study, and a dissertation are all included in the program. Students study subjects include pediatric pharmacology, family-centered care, child development, and healthcare policy. Research methods, mathematical modeling, and clinical evidence are highlighted throughout the curriculum. Graduates are equipped to take on leadership positions in academic institutions, centers for research, or clinical settings, improving pediatric nursing care by imaginative teaching and research.
Ph.D. in Community Health Nursing
The average time to finish a Ph.D. program in community health nursing is 4 - 5 years. Enhancing the practice of nursing, research, and leadership in community-based healthcare settings is the...
Ph.D. in Community Health Nursing
×The average time to finish a Ph.D. program in community health nursing is 4 - 5 years. Enhancing the practice of nursing, research, and leadership in community-based healthcare settings is the program's main goal. Evidence-based practice, program evaluation, health policy, and epidemiology are among the subjects addressed in the coursework. Graduates are equipped to take on positions as advanced practitioners, educators, and nurse scientists, spearheading advancements to enhance population health outcomes. An independently conducted dissertation that advances the area of community health nursing is the application's capstone.
Ph.D. in Pedodontics
A Ph.D. in Pedodontics is typically a 4-6 year program that provides advanced training in the specialized field of pediatric dentistry. Child psychology, behavior management, interceptive orthodont...
Ph.D. in Pedodontics
×A Ph.D. in Pedodontics is typically a 4-6 year program that provides advanced training in the specialized field of pediatric dentistry. Child psychology, behavior management, interceptive orthodontics, pediatric oral pathology, and the creation of novel treatment strategies for the particular oral health requirements of newborns, kids, and teenagers are among the subjects covered in the program. In order to further the scientific understanding of the factors impacting children's oral health and the creation of evidence-based preventive and restorative techniques, students frequently collaborate with community health centers, dentistry schools, or children's hospitals to perform original research. Graduates of this program are equipped for leadership positions in children oral health research and advocacy, pediatric dentistry practice, academics, and hospital-based dentistry. They can use their knowledge to increase access to quality dental care for children, promote early childhood oral health, and train the next generation of pediatric dental professionals.
Ph.D. in Medical Biotechnology
A Ph.D. in Medical Biotechnology typically takes 3-5 years to complete and focuses on applying biotechnological principles to medical research and healthcare innovations. On-depth laboratory resear...
Ph.D. in Medical Biotechnology
×A Ph.D. in Medical Biotechnology typically takes 3-5 years to complete and focuses on applying biotechnological principles to medical research and healthcare innovations. On-depth laboratory research combines with specialist education in molecular biology, genetics, biochemistry, and bioengineering. Students gain expertise in disciplines like gene therapy, regenerative medicine, drug research, and diagnostic technologies. Biostatistics, research ethics, and scientific writing are frequently covered in the curriculum. It is required of candidates to finish a dissertation, publish in peer-reviewed publications, and carry out unique research. Graduates of this program are prepared for positions in academia, pharmaceutical businesses, biotechnology firms, and research organizations, where they can use cutting-edge biotechnological solutions to improve patient care and contribute to ground-breaking medical discoveries.
Ph.D. in Medical Epidemiology
Ph.D. in Medical Epidemiology is a 3-5 year research program that studies the distribution, causes, and control of diseases in populations. It combines statistical analysis, public health, and clin...
Ph.D. in Medical Epidemiology
×Ph.D. in Medical Epidemiology is a 3-5 year research program that studies the distribution, causes, and control of diseases in populations. It combines statistical analysis, public health, and clinical medicine to better understand disease transmission, intervention efficacy, and health inequities. The program addresses topics such as illness prevention, outbreak investigation, risk factors, and epidemiological study design. Students develop skills in data analysis, biostatistics, epidemiological modeling, and research procedures. Graduates can work in academia, government health agencies, public health groups, or the pharmaceutical business, helping to prevent disease, develop health policies, and promote global health.
Ph.D. in Medical Gastroentrology
Ph.D. in Medical Gastroenterology is a 4-6 year research program that focuses on the digestive tract and its illnesses. It combines clinical gastroenterology, molecular biology, immunology, and pat...
Ph.D. in Medical Gastroentrology
×Ph.D. in Medical Gastroenterology is a 4-6 year research program that focuses on the digestive tract and its illnesses. It combines clinical gastroenterology, molecular biology, immunology, and pathology to investigate disorders such as inflammatory bowel disease (IBD), liver illnesses, colorectal cancer, gastrointestinal infections, and gut microbiota. The program focuses on illness processes, new diagnostic tools, treatment strategies, and advances in endoscopic procedures. Students develop knowledge of clinical trials, molecular diagnostics, and gastrointestinal physiology. Graduates can work in academic research, healthcare institutions, pharmaceuticals, and biotechnology, helping to advance digestive health and patient care.
Ph.D. in Medical Immunology
Ph.D. in Medical Immunology is a 3-5 year research-intensive program that researches the immune system and its function in human health and illness. The curriculum combines immunology, microbiology...
Ph.D. in Medical Immunology
×Ph.D. in Medical Immunology is a 3-5 year research-intensive program that researches the immune system and its function in human health and illness. The curriculum combines immunology, microbiology, molecular biology, and pathology to study immune responses to infections, cancer, autoimmune illnesses, and immunodeficiency. Students do cutting-edge research on issues such as immunological control, immunotherapy, vaccine development, and immune system illnesses. They gain experience in laboratory procedures like flow cytometry, ELISA, and cell culture. Graduates can pursue professions in academic research, biotechnology, pharmaceuticals, and public health, helping to enhance immunological treatments and therapies.
Ph.D. in Medical Neurology
Ph.D. in Medical Neurology is a 4-6 year research-focused program dedicated to studying the nervous system and its disorders. It combines clinical neurology, molecular biology, neuroimmunology, and...
Ph.D. in Medical Neurology
×Ph.D. in Medical Neurology is a 4-6 year research-focused program dedicated to studying the nervous system and its disorders. It combines clinical neurology, molecular biology, neuroimmunology, and neurophysiology to explore diseases such as Alzheimer's, Parkinson's, epilepsy, stroke, and neurodegenerative conditions. The program emphasizes research on disease mechanisms, biomarkers, neuroplasticity, and novel therapeutic approaches. Students gain expertise in diagnostic techniques, neuroimaging, and clinical trials, contributing to advancements in neurology and patient care. Graduates can pursue careers in academic research, clinical practice, pharmaceutical companies, and healthcare institutions, advancing the understanding and treatment of neurological diseases.
Ph.D. in Medical Parasitology
Ph.D. in Medical Parasitology is a 3-5 year research program focused on parasites that affect human health. The curriculum brings together parasitology, microbiology, immunology, and molecular biol...
Ph.D. in Medical Parasitology
×Ph.D. in Medical Parasitology is a 3-5 year research program focused on parasites that affect human health. The curriculum brings together parasitology, microbiology, immunology, and molecular biology to investigate the biology, pathophysiology, and transmission of parasitic illnesses such malaria, leishmaniasis, and schistosomiasis. Students learn about diagnostic procedures, parasite-host relations, epidemiology, and the development of new therapies and vaccinations. Drug resistance, vector control, and new parasitic illnesses are all potential research fields. Graduates can work in academia, public health, pharmaceutical businesses, or international health organizations, helping to develop parasitic disease prevention and treatment.
Ph.D. in Medical Statistics
Ph.D. in Medical Statistics is a 3-5 year research-intensive program that focuses on using statistical approaches in medical and clinical research. It integrates advanced statistical theory with re...
Ph.D. in Medical Statistics
×Ph.D. in Medical Statistics is a 3-5 year research-intensive program that focuses on using statistical approaches in medical and clinical research. It integrates advanced statistical theory with real-world applications in health data analysis, clinical trials, epidemiology, and public health research. The program includes topics such as survival analysis, bioinformatics, statistical modeling, clinical trial design, and complex health data interpretation. Students learn statistical tools, experimental design, and data analysis procedures, which help to advance evidence-based medicine and healthcare decision-making. Graduates can work in academia, government agencies, healthcare institutes, and pharmaceutical firms, improving statistical methods in medical research.
Ph.D. in Medical Virology
Ph.D. in Medical Virology is a 3-5 year research program with an emphasis on viruses that affect human health. It uses molecular biology, microbiology, immunology, and epidemiology to investigate v...
Ph.D. in Medical Virology
×Ph.D. in Medical Virology is a 3-5 year research program with an emphasis on viruses that affect human health. It uses molecular biology, microbiology, immunology, and epidemiology to investigate viral pathogenesis, replication, and transmission. The curriculum focuses on topics such as viral infections, antiviral medicines, vaccine development, and diagnostic technologies. Students become proficient in virology techniques such as PCR, sequencing, and viral culture while doing research on viral diseases such as HIV, hepatitis, influenza, and new viruses such as COVID 19. Graduates can work in academia, public health, pharmaceutical businesses, or government research groups to improve the understanding and treatment of viral diseases.